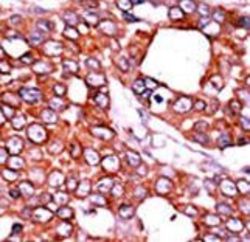

Antibody data
- Antibody Data
- Antigen structure
- References [0]
- Comments [0]
- Validations
- Western blot [2]
- Immunohistochemistry [3]
Submit
Validation data
Reference
Comment
Report error
- Product number
- LS-C97430 - Provider product page

- Provider
- LSBio
- Product name
- CDC25A Antibody (phospho-Thr507) LS-C97430
- Antibody type
- Polyclonal
- Description
- Protein A purified
- Reactivity
- Human
- Host
- Rabbit
- Storage
- Maintain refrigerated at 2°C to 8°C for up to 6 months. For long term storage store at -20°C.
No comments: Submit comment
Enhanced validation
- Submitted by
- LSBio (provider)
- Enhanced method
- Genetic validation
- Main image

- Experimental details
- Western blot of extracts from HeLa cells, untreated or treated with calyculin A, using Phospho-Cdc25A Antibody (T507).
- Submitted by
- LSBio (provider)
- Enhanced method
- Genetic validation
- Main image

- Experimental details
- The anti-Phospho-CDC25A-T507 antibody is used in Western blot to detect Phospho-CDC25A-T507 in cells transfected with wild type or mutant T507 A of CDC25A. Data courtesy of Dr. Tiebang Kang of Washington University, St. Louis, MO.
Enhanced validation
- Submitted by
- LSBio (provider)
- Enhanced method
- Genetic validation
- Main image

- Experimental details
- Formalin-fixed and paraffin-embedded human cancer tissue reacted with the primary antibody, which was peroxidase-conjugated to the secondary antibody, followed by AEC staining. This data demonstrates the use of this antibody for immunohistochemistry; clinical relevance has not been evaluated. BC = breast carcinoma; HC = hepatocarcinoma.
- Submitted by
- LSBio (provider)
- Enhanced method
- Genetic validation
- Main image

- Experimental details
- Formalin-fixed and paraffin-embedded human cancer tissue reacted with the primary antibody, which was peroxidase-conjugated to the secondary antibody, followed by AEC staining. This data demonstrates the use of this antibody for immunohistochemistry; clinical relevance has not been evaluated. BC = breast carcinoma; HC = hepatocarcinoma.
- Submitted by
- LSBio (provider)
- Main image
- Experimental details
- Formalin-fixed and paraffin-embedded human cancer tissue reacted with the primary antibody, which was peroxidase-conjugated to the secondary antibody, followed by AEC staining. This data demonstrates the use of this antibody for immunohistochemistry; clinical relevance has not been evaluated. BC = breast carcinoma; HC = hepatocarcinoma.